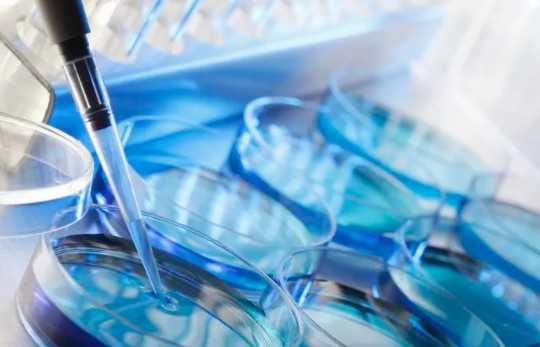
国内代怀医院费用多少,孕妇吃腌制食物对胎儿健康有影响,内附孕期饮食注意事项

作者:admin
日期:2025-05-30
孕期吃腌制食品对胎儿健康的影响
腌制食品中含有大量盐分和亚硝酸盐等物质,而这些物质如果被孕妇长期摄入,则会影响到胎儿的健康。一方面,盐分过多会导致孕妇体内水分过多,增加肾脏负担并引起高血压;另一方面,亚硝酸盐也会对胎儿的血液循环、神经系统、生殖系统等产生影响。因此孕期最好少吃或者避免吃腌制食品。在购买或自制腌制食品时也需要格外小心。由于这类食品往往保存时间较长,易滋生细菌和霉菌,并产生亚硝胺等致癌物质。因此建议孕妇在购买这类食品时选择正规渠道的品牌或者自制时注意卫生标准和保存时间。有哪些食物可以代替腌制食品?
虽然孕妇需要避免吃腌制食品,但并不意味着她们要放弃口感上的享受。以下是一些可替代腌制食品的健康食物:
1、新鲜水果:新鲜的水果含有丰富的维生素和矿物质,并能够帮助缓解孕期便秘问题。2、坚果:坚果中含有丰富的不饱和脂肪酸、纤维素等营养成分,还能提供人体所需的氨基酸和微量元素等。3、红枣:红枣中含有大量铁元素、维生素C等营养成分,对于孕妇而言具有很好的补血功效。4、酸奶:酸奶中含有丰富的乳酸菌、钙等营养成分,可以增强孕妇身体抵抗力,并促进胎儿发育。孕期饮食的注意事项
除了避免吃腌制食品外,孕妇在日常饮食中还需要注意以下几点:
1、均衡摄入各种营养素:包括蛋白质、碳水化合物、脂肪、维生素和矿物质等。2、多吃水果和蔬菜:这些食物富含维生素和矿物质,可以帮助提高孕妇身体免疫力,并促进胎儿发育。3、避免过度进食:过度进食可能会导致胎儿体重增加过快,从而加重分娩难度。4、注意饮食卫生:购买或自制食品时要注意卫生标准,并尽量避免生冷食物。 孕期饮食孕期食谱孕期健康孕期护理国内可以供卵的私人医院,2026国内外三代试管婴儿选性别费用,附国内试管筛选性别的要求!
国内如何接受供卵,2026年单身去海外做试管婴儿大约需要多少钱?
国内医院供卵费用,2026试管婴儿收费价目表,一、二、三代费用明细参考!
国内大医院哪家供卵比较好,【生育指南】:2026厦门安宝医院做三代试管费用大约要花多少?
国内可以供卵试管婴儿的公司,2026国家卫计委对生三胎有哪些新的奖励政策?看这篇就够了
国内捐卵子咨询,2026年马来西亚比较好的试管婴儿医院哪个比较好
国内可靠的供卵医院排名,2026年第三代试管选性别费用十五万够吗
国内供卵交流,圣元奶粉六大系列价格解析(圣元奶粉价格表2026)
国内知名的代孕,不生孩子要交税吗2026年丁克税单子税怎么收
国内代孕首选,2026珠海三代试管哪个医院好已揭晓?用住院么!